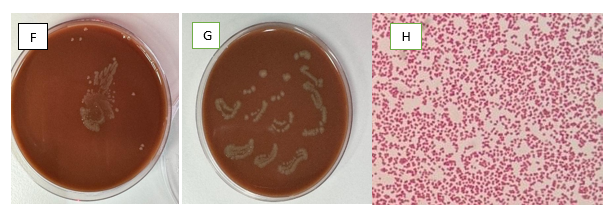

Advances in
eISSN: 2377-4290


Case Report Volume 16 Issue 1
1Department of Ophthalmology, Sheikh Khalifa Medical City, United Arab Emirates
2Department of Infectious Disease, Zayed Military Hospital, United Arab Emirates
3Department of Ophthalmology, Zayed Military Hospital, United Arab Emirates
Correspondence: Dr. Amna AlMaazmi, Consultant Ophthalmology Surgeon, Division Chief Department of Ophthalmology, Zayed Military Hospital, Coastal Road, Abu Dhabi, United Arab Emirates, Tel +971 2 4055333
Received: December 26, 2025 | Published: January 12, 2026
Citation: Alalawi F, Alalawi L. Hassan N, et al. Unveiling the uncommon: a case report on primary Neisseria meningitidis keratitis. Adv Ophthalmol Vis Syst. 2026;16(1):5-7. DOI: 10.15406/aovs.2026.16.00499
Purpose: To report an atypical case of primary meningococcal keratitis in a myopic contact lens wearer, with typical clinical features resembling acanthamoeba keratitis. This case report emphasizes the significance of early diagnosis, investigations, and management of primary meningococcal keratitis.
Case-report: This is a single-patient case report describing an 18-year-old male, contact lens wearer, who presented with 1 month history of left eye redness, and discomfort. His initial exam showed a semi-ring-shaped infiltrate, and cultures confirmed the presence of Neisseria meningitidis.
Results: Based on the initial clinical suspicion of acanthamoeba keratitis, the patient was managed by total superficial keratectomy, which was sent for corneal gram stain, culture and histopathology. Topical hourly moxifloxacin hydrochloride ophthalmic solution 0.5% and propamidine isotheonate 0.1% ophthalmic solution and chlorhexidine gluconate 0.02% ophthalmic solution. Following the culture confirmed pathogen, infectious disease team was consulted and a systemic treatment with 7 days of intravenous ceftriaxone 2 grams per day was given. He had persistent epithelial defect that resolved after 3 weeks from the initial visit on intense regimen of ocular lubrication.
Conclusion: This case report highlights an atypical presentation of culture confirmed primary neisseria meningitidis keratitis presenting with a ring-shaped infiltrate. Misdiagnosis or inappropriate treatment, such as the use of steroids, can exacerbate the condition. When evaluating contact lens wearers presenting with a ring-shaped infiltrate, n. meningitidis may be considered as a potential causative pathogen. However, in view of both the potential ocular and systemic sequelae of n. meningitidis infection, it is important to investigate and treat these patients promptly and aggressively.
Keywords: corneal ulcer, keratitis, conjunctivitis, Neisseria meningitidis
Neisseria meningitidis (NM) is a fastidious, encapsulated, gram-negative diplococcus that causes life threatening blood septicemia with preference towards the meninges resulting in meningitis. Meningitis and meningococcemia are the classical presentations of meningococcal disease, however, asymptomatic nasopharyngeal colonization with up to 10% of the general population carrying the bacteria in their nose and throat without experiencing any adverse effects.1,2 Increased rates are detected in smokers, overcrowded households, and military recruits. Primary meningococcal conjunctivitis (PMC) is a rare form of acute, purulent bacterial conjunctivitis, with children more commonly affected than adults. The reported incidence rate ranges from <0.08% to 2.0%, though these figures are likely underestimated due to the infrequent collection of cultures in uncomplicated cases.3 Prompt recognition and systemic antibiotic treatment are critical, as systemic involvement can be life-threatening.
PMC results from the direct inoculation of meningococci into the conjunctival sac, either through direct contact or via airborne transmission. While most cases of PMC resolve with appropriate treatment, complications such as corneal ulcers, subconjunctival hemorrhage, and iritis have been documented.
Here, we describe a case of culture confirmed primary meningococcal keratitis (PMK), primarily affecting the cornea in an adult patient who presented with clinical signs and symptoms resembling acanthamoeba corneal keratitis.
An eighteen-year-old male, equestrian rider, presented to the outpatient clinic with left severe eye pain, redness, tearing, photophobia and blurring of vision for 3 weeks. He is a myopic contact lens wearer, with poor contact lens hygiene. Before presenting to our cornea service, he was treated elsewhere for bacterial conjunctivitis with topical ciprofloxacin and steroid drops, which exacerbated his symptoms. He denied any recent traveling and close contact with unwell individuals. His initial distance visual acuity with correction was 6/6 for the right eye, and 6/24 left eye. Corneal sensation was intact. Slit-lamp examination of the right eye revealed blepharitis and scars of previous marginal keratitis. However, the left eye showed increased lacrimation and marked ciliary injection. The left cornea had a superior paracentral infiltrate, with positive fluoresceine uptake, measuring 0.5x0.5 mm and an early semi- ring infiltrate associated with limbitis. The corneal epithelium had an unhealthy appearance, upper and lower palpebral conjunctiva with hyperemia (Figures 1A–1D).

Figure 1A–B Clinical slit lamp images of the left cornea with a superior paracentral infiltrate (yellow arrow), with positive fluoresceine uptake, measuring 0.5x0.5 mm and an early semi- ring infiltrate associated with limbitis ( yellow arrow). The corneal epithelium had an unhealthy appearance.
Slit-lamp examination revealed +1 anterior chamber cells per the SUN Working Group criteria, with an unremarkable dilated posterior segment examination. A total superficial keratectomy extending from limbus to limbus was performed at the slit lamp. Corneal scrapings were obtained and sent for Gram stain, culture, and histopathology, and the patient’s left contact lens was retrieved for further analysis. The patient was admitted and an empiric treatment of topical hourly moxifloxacin hydrochloride ophthalmic solution 0.5% and propamidine isotheonate 0.1% ophthalmic solution and chlorhexidine gluconate 0.02% ophthalmic solution was started on a high suspicion of acanthamoeba. Topical therapy was initiated with loading doses administered every five minutes in the clinic and subsequently continued on an hourly basis during hospitalization. Cyclopentolate 1% ophthalmic solution was given three times a day for pain management. Corneal scraping was done by total superficial keratectomy, limbus to limbus, the excised tissue obtained were submitted for Gram staining, histopathology, and microbiological culture. Specimens were inoculated onto blood agar, chocolate agar, Sabouraud dextrose agar, non-nutrient agar with Escherichia coli, and thioglycollate broth. Contact lens was directly inoculated onto chocolate agar plates. Within 24hours the cultures from the patient’s own lenses and corneal scrapings grew gram negative diplococci NM which was sensitive to ceftriaxone and resistant to ciprofloxacin (Figures 1E–1H).
Figure 1F–H Chocolate agar with heavy growth from the patient’s own contact lens and corneal scrapping respectively. The gram stain confirmed a gram negative diplococci bacteria consistent with Neisseria meningitidis.
The patient demonstrated clinical improvement within 24 hours of initiating topical therapy, topical treatment regimen was continued for 2 weeks. Although the patient had no systemic signs or symptoms, he was treated prophylactically with 2g intravenous systemic ceftriaxone every day for 7 days as per the control strategy of invasive meningococcal disease within the United Arab Emirates2. The previously observed superior infiltrate had resolved, leaving behind a faint superior paracentral haze (Figures 1I–1J) while the corneal epithelial defect exhibited slow healing (Figure 1E). The conjunctival and ciliary injection subsided. His blood culture was negative for any growth.
They have conducted an investigation into the case, gathering details on the clinical presentation, potential source of infection, vaccination status, and disease outcome among close contacts of our patient. In accordance with public health recommendations, chemoprophylaxis is generally reserved for close contacts of patients with invasive meningococcal disease. Household and close contacts were contacted and offered ceftriaxone as a chemoprophylaxis. Our case is unusual because it developed in a young healthy male, with an unclear source of infection, with no history of contact with people infected with NM. NM is classically associated with invasive systemic disease, isolated ocular infection without systemic manifestations has been reported PMC/PMK is believed to result from direct inoculation of the ocular surface, particularly in contact lens wearers.9 In such cases, the organism remains confined to the ocular surface, without bacteremia, explaining the absence of fever, rash, neck pain, or other systemic features.10 Similar presentations of localized PMC in otherwise healthy individuals without systemic involvement have been described in the literature. Interestingly, a previously reported case series by a group in Singapore described NM isolates from 2 patients presentenced with corneal ulceration.11
The topical treatment for each patient was different with the first patient treated with hourly levofloxacin (0.5%) and cefazolin (50 mg/mL) eye drop and the second patient with cefazolin (50 mg/mL) and gentamicin (14 mg/mL) eye drops hourly. In both of these cases the corneal ulcer healed with only residual scaring. Early recognition of PMC/PMK is crucial, as ocular complications can include corneal ulceration. Additionally, 10–29% of cases risk progressing to life-threatening systemic meningococcal infection within four days (ranging from 3 hours to 4 days) after conjunctivitis onset, with a fatality rate of 13%.12,13 Systemic treatment of intravenous ceftriaxone is the first-line treatment for meningococcal infections and oral rifampicin twice daily for total of 4 days is recommended as chemoprophylaxis for close contacts and household members.13 Mortality rate is 13 % among patients with systemic diseases.14 Due to the high mortality rate, universal immunization programs have been implemented worldwide, leading to a decline in the incidence of these diseases.15
It is uncommon to have keratitis associated NM, the number of cases reported that in isolation to conjunctivitis is limited in literature. The living environment and the growing use of contact lenses should alert the clinician to possible other causative organisms.
None.
The author declares that there are no conflicts of interest.
None.

©2026 Alalawi, et al. This is an open access article distributed under the terms of the, which permits unrestricted use, distribution, and build upon your work non-commercially.